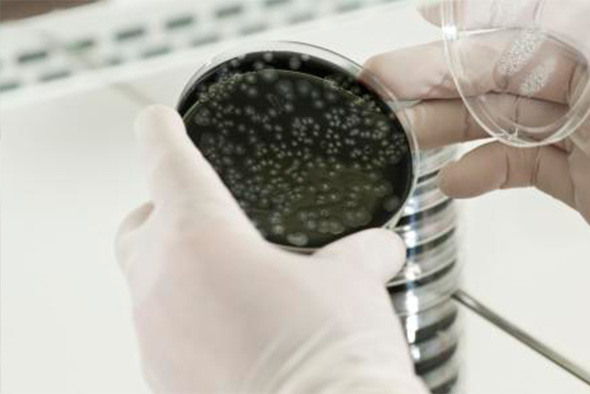

Desde hace tiempo, AQUA´STUDIO 2004, es sinónimo de prestigio en la investigación y desarrollo de todo lo concerniente a los tratamientos de agua y aire en instalaciones de riesgo frente a la Legionella y al COVID-19.
Durante los últimos años, la Legionella y más recientemente el Coronavirus, se han hecho muy presentes en los medios de comunicación…estos virus y bacterias cuyo habitat es el aire y en el caso de la Legionella incluso el agua, son capaces como estamos tristemente comprobando, de extenderse muy rápidamente pudiendo llegar a provocar la muerte.
Tratamos todo tipo de conductos de aire acondicionado, climatizado, etc, con el fin de evitar la transmisión de enfermedades infecciosas que se propagan a través del aire, entre ellas el tan tristemente actual Coronavirus COVID-19, gripe común, gripe a-h1n1, alergias, catarros, etc.